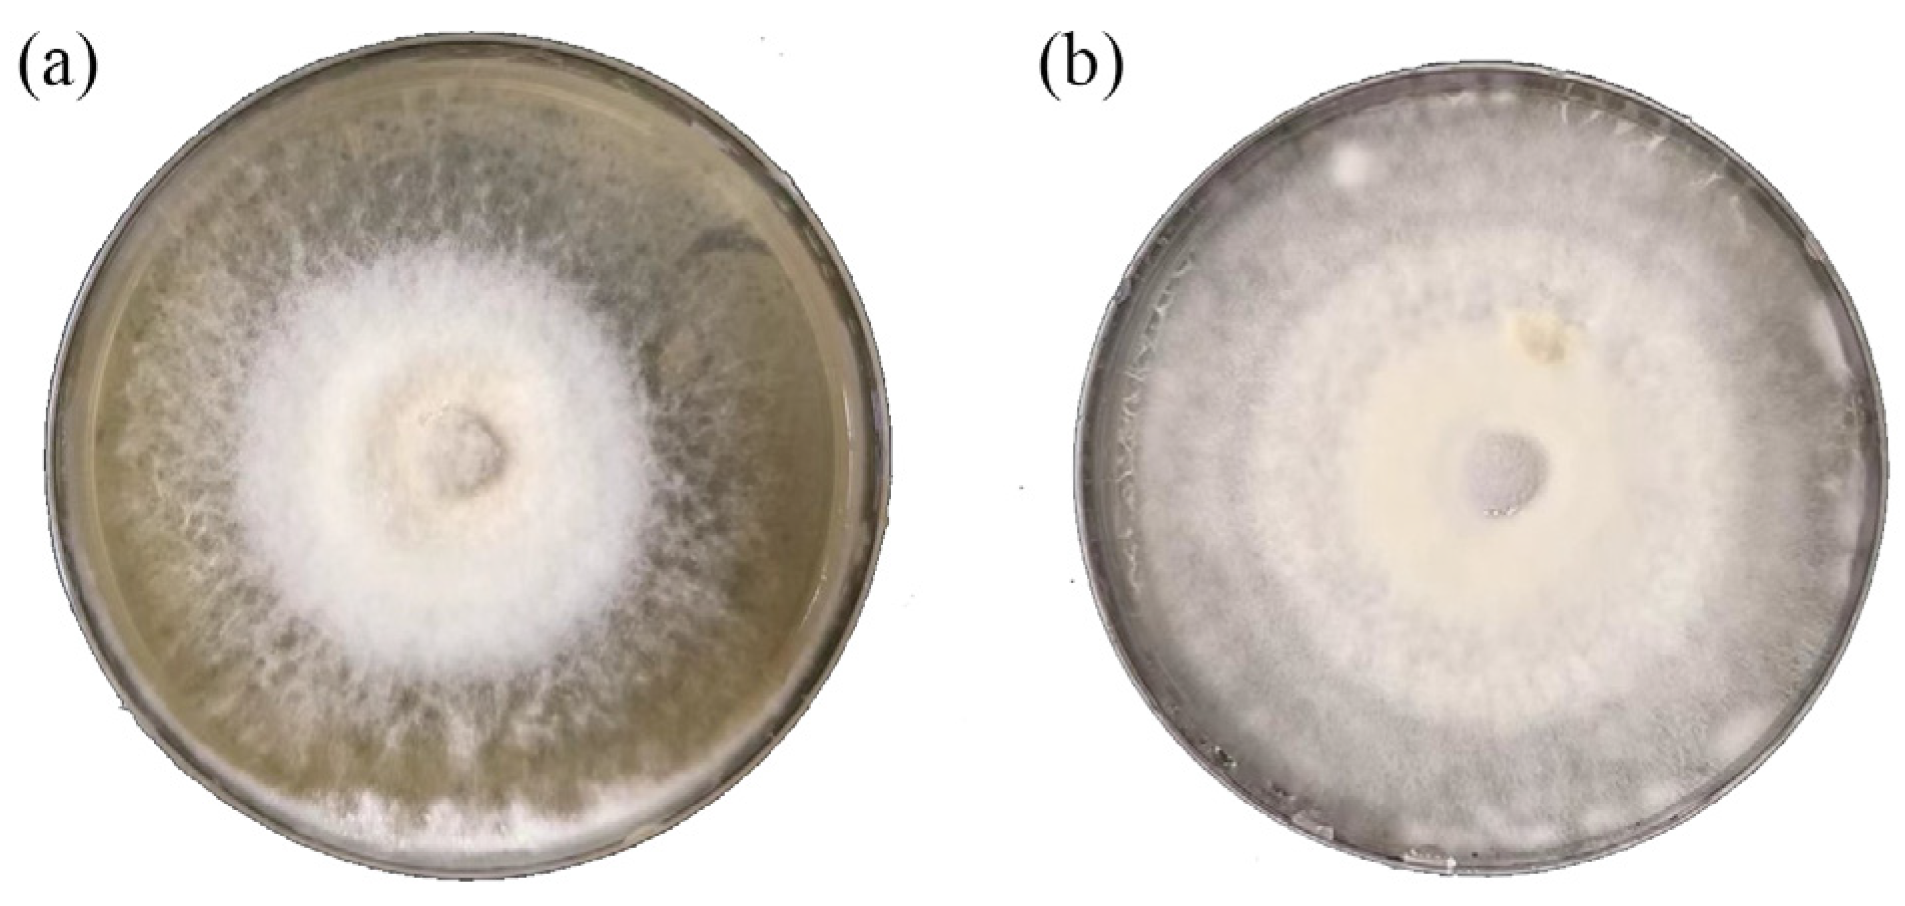
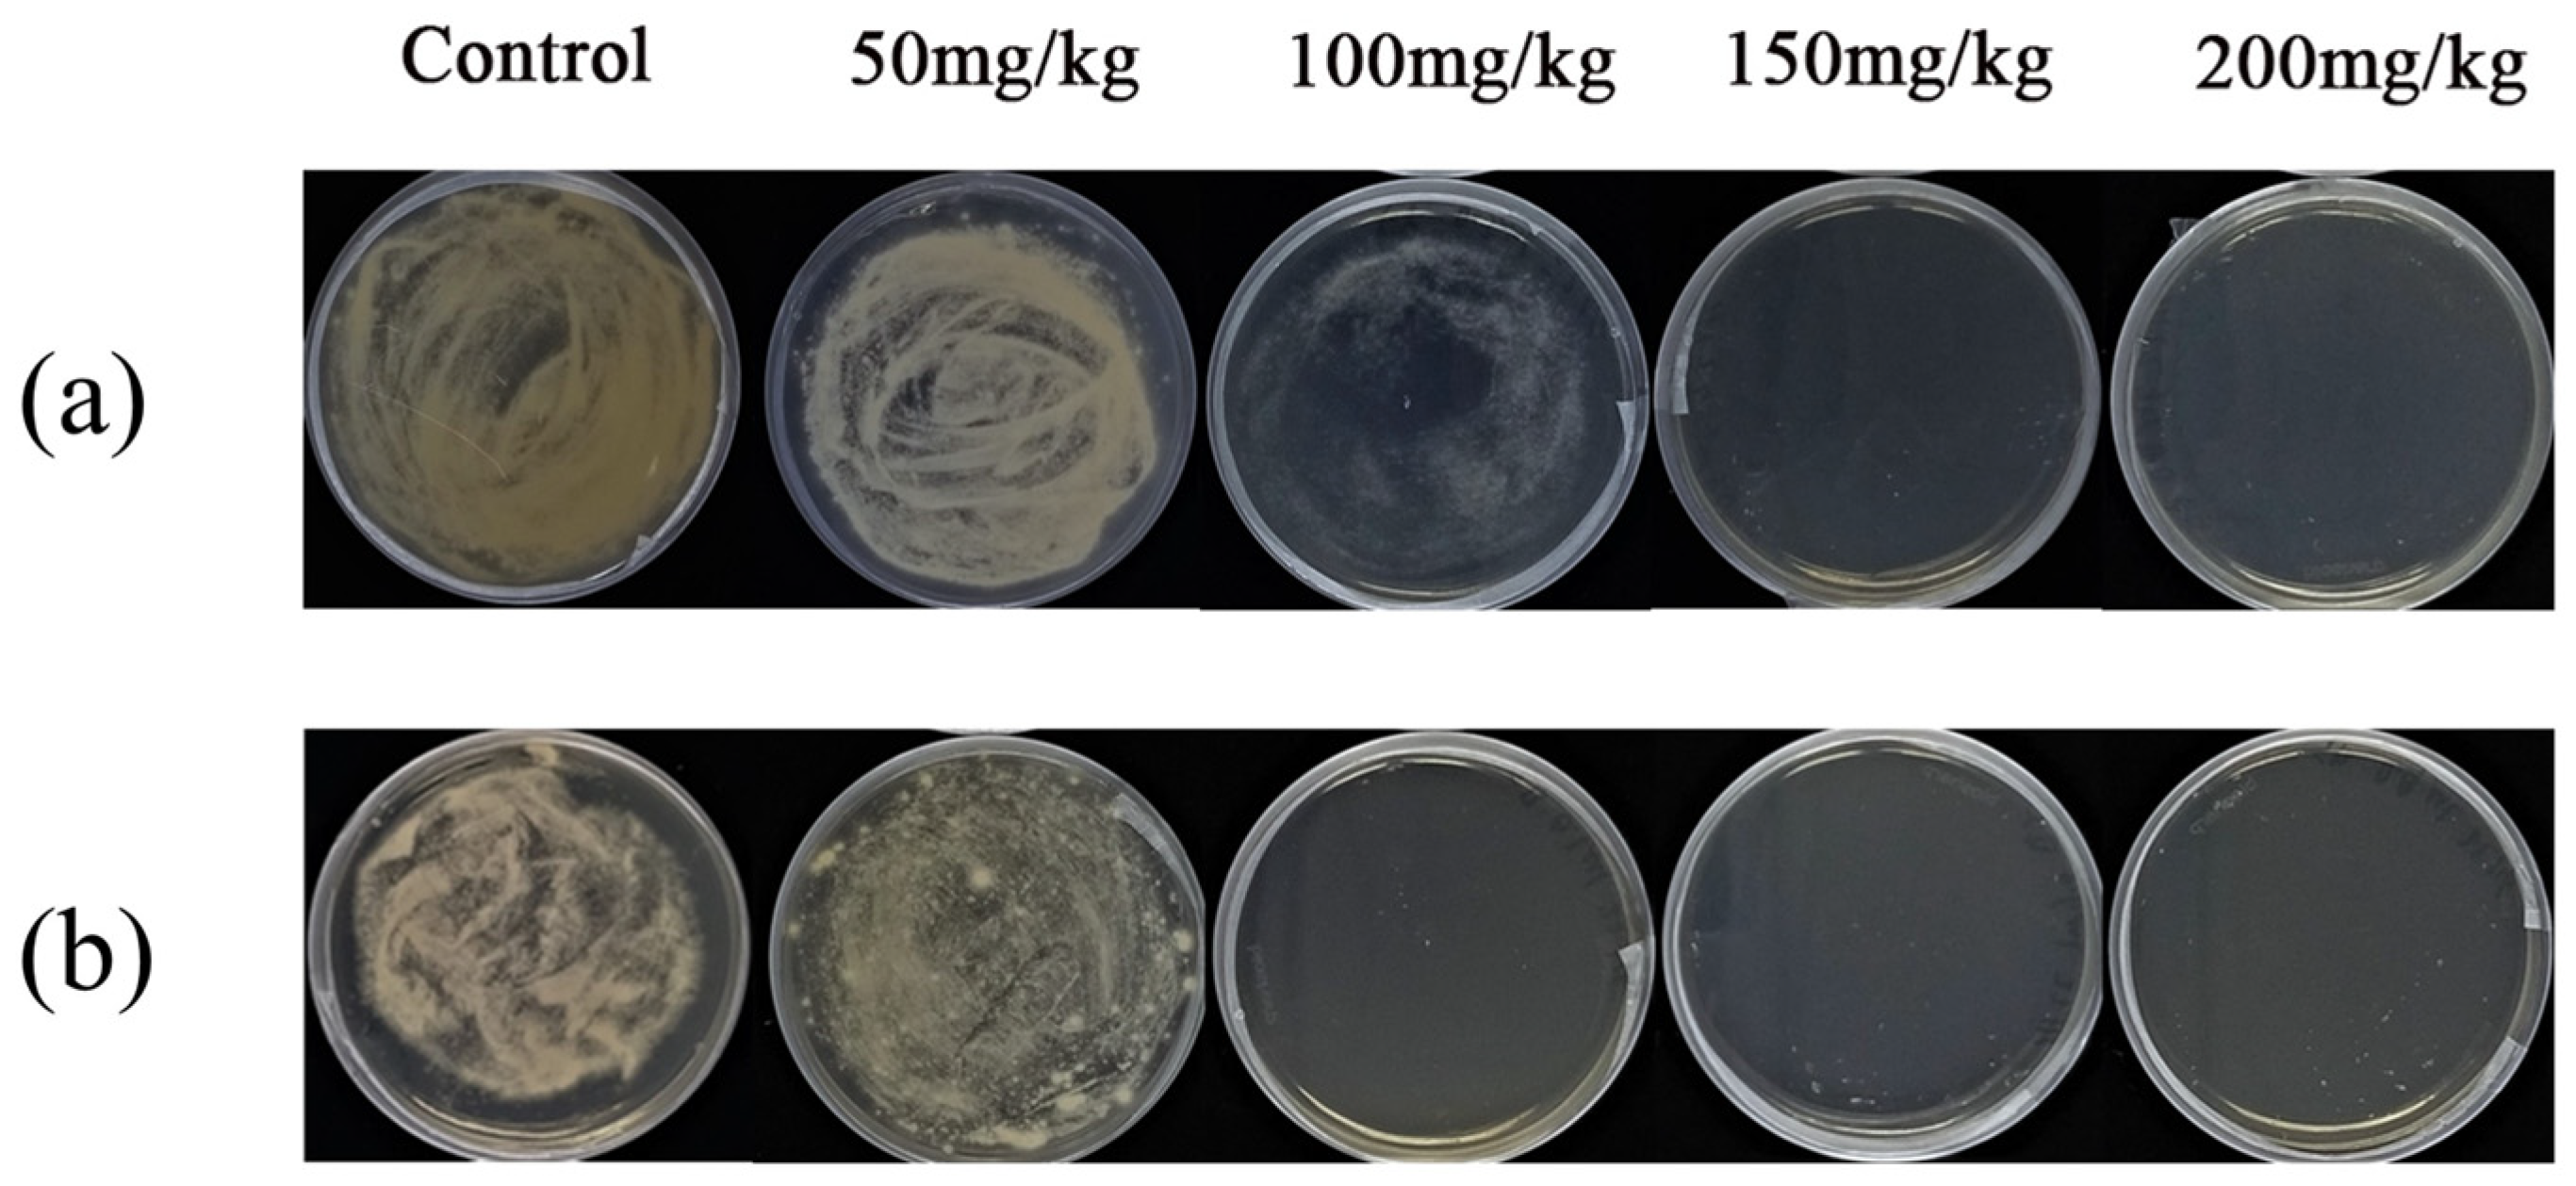
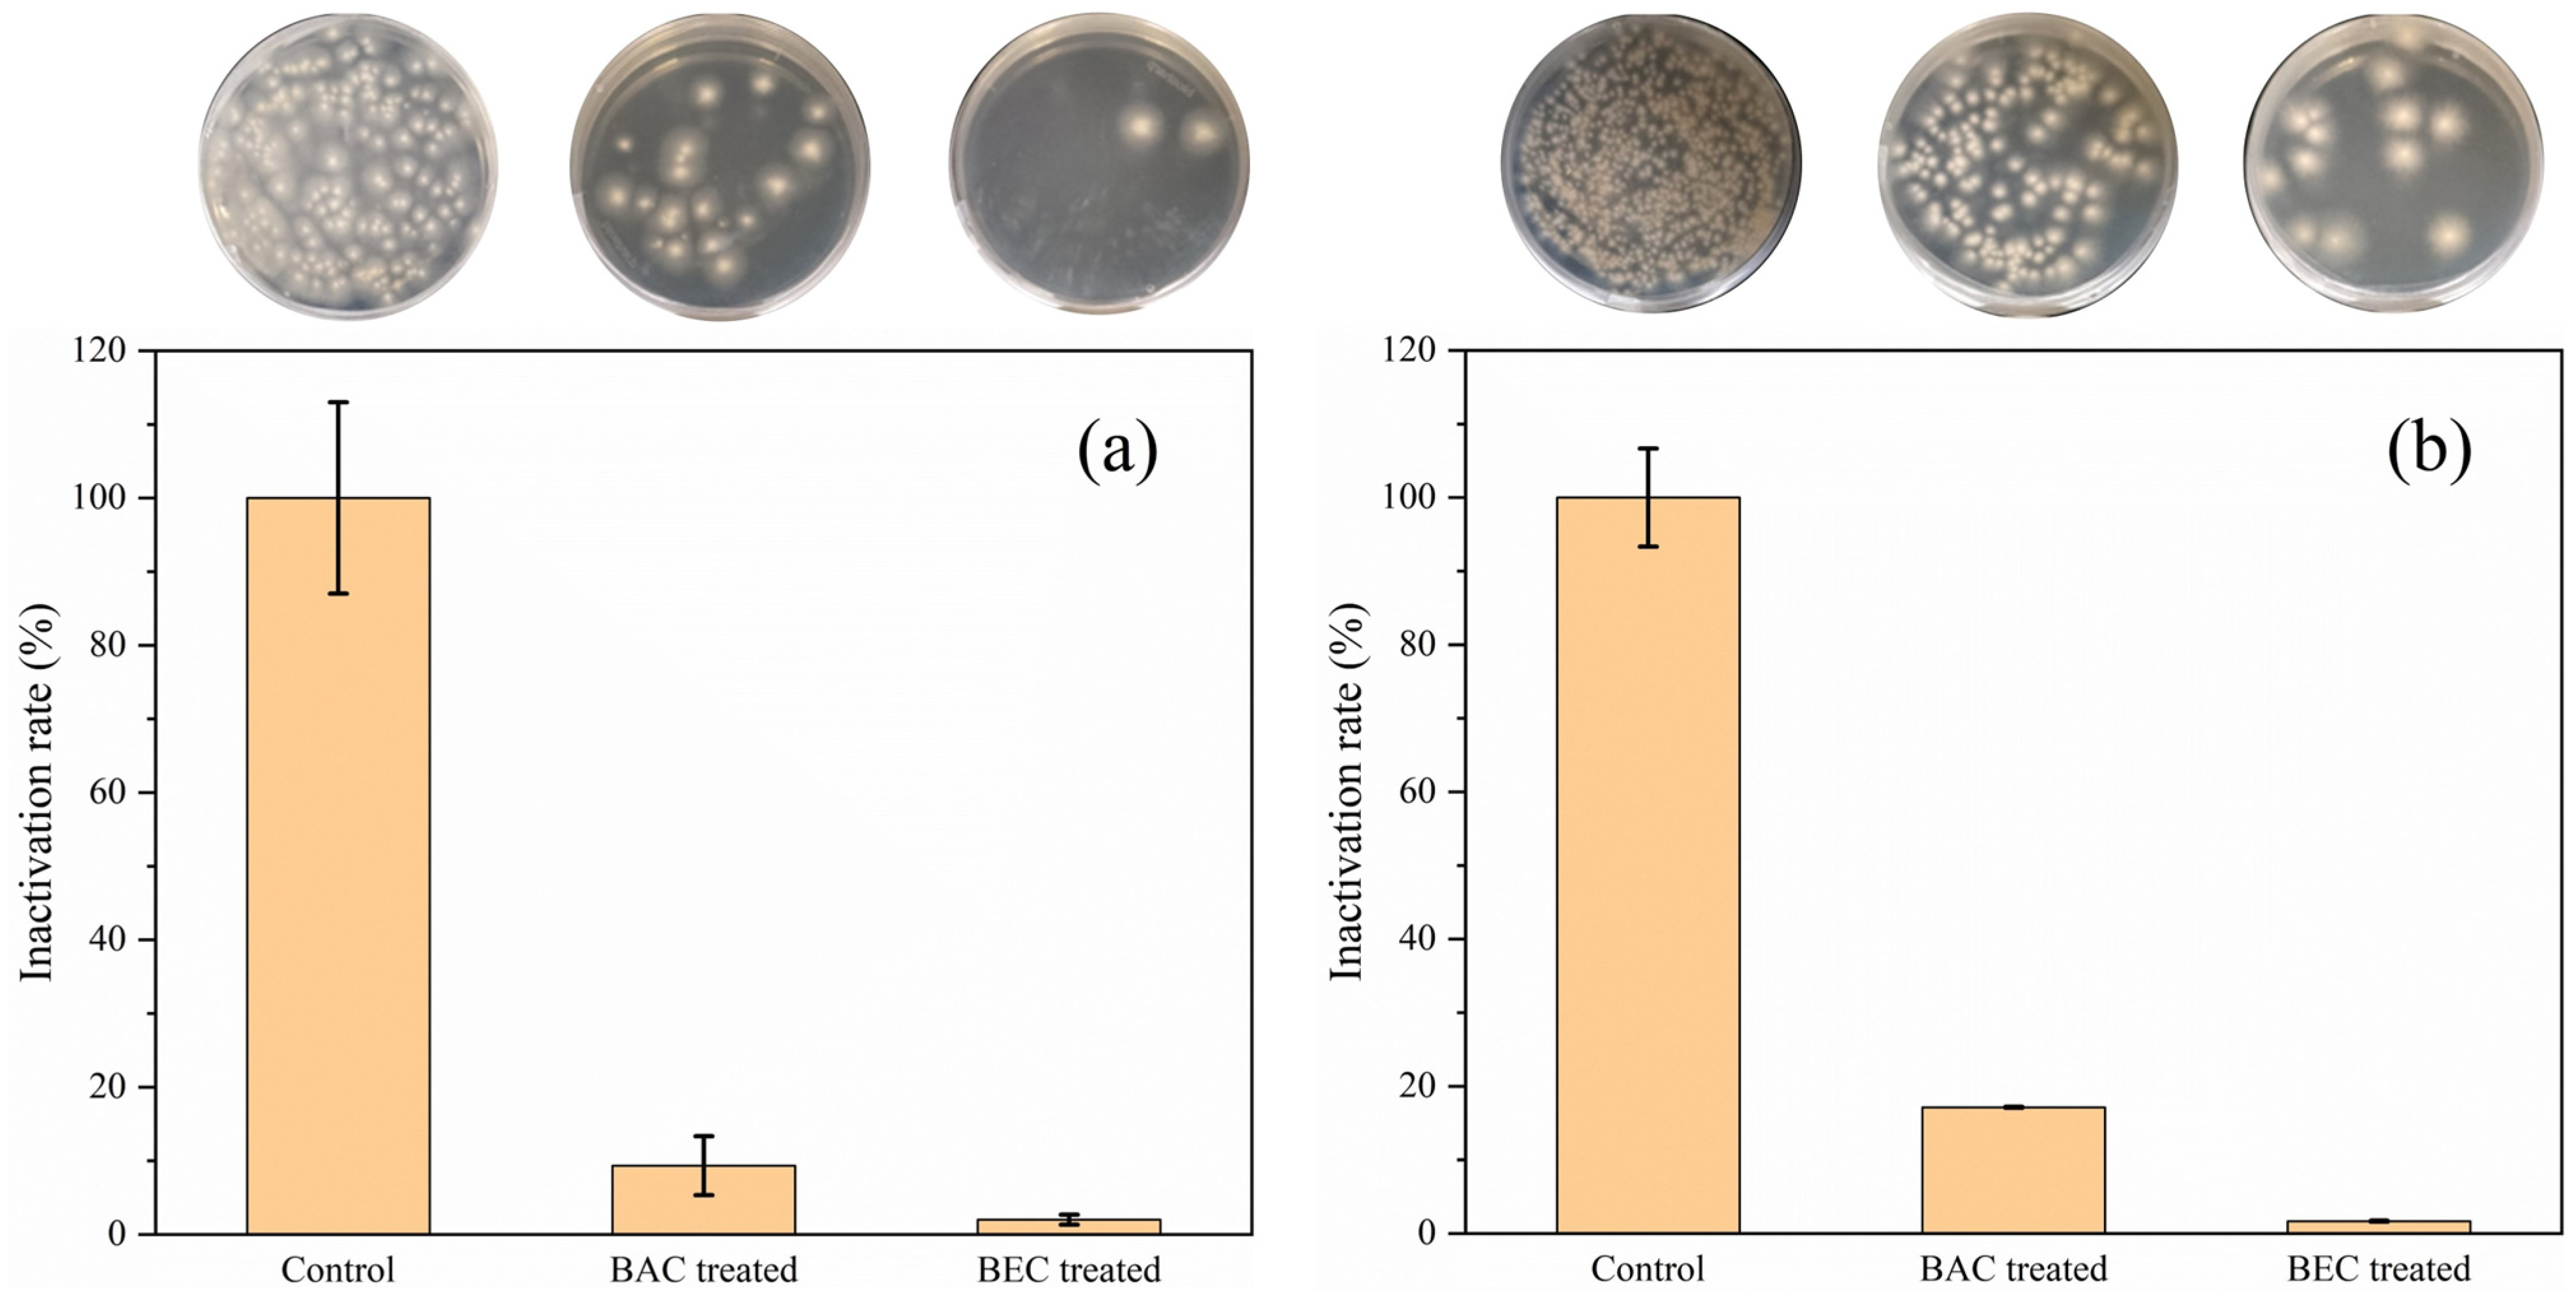

Benzalkonium Chloride and Benzethonium Chloride Effectively Reduce Spore Germination of Ginger Soft Rot Pathogens: Fusarium solani and Fusarium oxysporum
Abstract
1. Introduction
2. Materials and Methods
2.1. Isolation and Characterization of Pathogenic Fungi
2.2. Preparation of Spore Suspensions
2.3. Chloropicrin Soil Sterilization Experiment
2.4. Colony Growth Inhibition of F. solani and F. oxysporum by BAC and BEC
2.5. Spore Inactivation Experiment
2.6. Methods Used for Observation of Changes in Spore Activity
2.6.1. Laser Confocal Microscopy Observation
2.6.2. Flow Cytometry Analysis
2.6.3. Scanning Electron Microscopy (SEM) Morphological Observations
2.6.4. Determination of Regrowth Potential
3. Results and Discussion
3.1. Identification of Pathogenic Fungi in Ginger
3.2. Antifungal Effect of Chloropicrin in Soil
3.3. Mycelial Growth Inhibitory Concentration of BAC and BEC
3.4. Changes in Spore Activity
3.5. Changes in Spore Surface Morphology and Structure
3.6. Regrowth Potential after BAC/BEC Treatment of Spores
3.7. Discussion
4. Conclusions
Supplementary Materials
Author Contributions
Funding
Institutional Review Board Statement
Informed Consent Statement
Data Availability Statement
Acknowledgments
Conflicts of Interest
References
- Swetha Priya, R.; Subramanian, R.B. Isolation and molecular analysis of R-gene in resistant Zingiber officinale (ginger) varieties against Fusarium oxysporum f.sp. zingiberi. Bioresour. Technol. 2008, 99, 4540–4543. [Google Scholar] [CrossRef] [PubMed]
- Wang, Y.; Yang, X.; Xu, M.; Geissen, V. Effects of chloropicrin fumigation and azoxystrobin application on ginger growth and phosphorus uptake. Ecotoxicol. Environ. Saf. 2022, 232, 113246. [Google Scholar] [CrossRef] [PubMed]
- Yan, D.; Wang, Q.; Li, Y.; Guo, M.; Guo, X.; Ouyang, C.; Migheli, Q.; Xu, J.; Cao, A. Efficacy and economics evaluation of seed rhizome treatment combined with preplant soil fumigation on ginger soilborne disease, plant growth, and yield promotion. J. Sci. Food Agric. 2022, 102, 1894–1902. [Google Scholar] [CrossRef] [PubMed]
- Srinivasan, V.; Thankamani, C.K.; Dinesh, R.; Kandiannan, K.; Hamza, S.; Leela, N.K.; John Zachariah, T. Variations in Soil Properties, Rhizome Yield and Quality as Influenced by Different Nutrient Management Schedules in Rainfed Ginger. Agric. Res. 2019, 8, 218–230. [Google Scholar] [CrossRef]
- Chawla, S.; Rafie, R.; Likins, M.; Ren, S.; Ndegwa, E.; Mersha, Z. First Report of Fusarium Yellows and Rhizome Rot Caused by Fusarium oxysporum f. sp. zingiberi on Ginger in the Continental United States. Plant Dis. 2021, 105, 3289. [Google Scholar] [CrossRef]
- Li, Y.; Chi, L.D.; Mao, L.G.; Yan, D.D.; Wu, Z.F.; Ma, T.T.; Guo, M.X.; Wang, Q.X.; Ouyang, C.B.; Cao, A.C. First Report of Ginger Rhizome Rot Caused by Fusarium oxysporum in China. Plant Dis. 2013, 98, 282. [Google Scholar] [CrossRef] [PubMed]
- Ajilogba, C.F.; Babalola, O.O. Integrated Management Strategies for Tomato Fusarium Wilt. Biocontrol Sci. 2013, 18, 117–127. [Google Scholar] [CrossRef] [PubMed]
- Peng, H.; Hu, H.; Xi, K.; Zhu, X.; Zhou, J.; Yin, J.; Guo, F.; Liu, Y.; Zhu, Y. Silicon Nanoparticles Enhance Ginger Rhizomes Tolerance to Postharvest Deterioration and Resistance to Fusarium solani. Front. Plant Sci. 2022, 13, 816143. [Google Scholar] [CrossRef]
- Ristaino, J.B.; Thomas, W. Agriculture, Methyl Bromide, and the Ozone Hole: Can We Fill the Gaps? Plant Dis. 1997, 81, 964–977. [Google Scholar] [CrossRef]
- Martin, F.N. Development of alternative strategies for management of soilborne pathogens currently controlled with methyl bromide. Annu. Rev. Phytopathol. 2003, 41, 325–350. [Google Scholar] [CrossRef]
- Preisser, A.M.; Budnik, L.T.; Baur, X. Health effects due to fumigated freight containers and goods: How to detect, how to act. Int. Marit. Health 2012, 63, 133–139. [Google Scholar] [PubMed]
- Suwanlaong, K.; Phanthumchinda, K. Neurological manifestation of methyl bromide intoxication. J. Med. Assoc. Thai. 2008, 91, 421–426. [Google Scholar] [PubMed]
- Park, M.-G.; Hong, Y.-S.; Park, C.G.; Gu, D.-C.; Mo, H.-h. Variations in methyl bromide concentration with distance and time during quarantine fumigation. Environ. Monit. Assess. 2021, 193, 397. [Google Scholar] [CrossRef] [PubMed]
- Fang, W.; Liu, X.; Song, Z.; Jin, X.; Yan, D.; Wang, Q.; Li, Y.; Cao, A. Mechanism of the antifungal action of chloropicrin fumigation against Panax notoginseng root rot caused by Fusarium solani. Physiol. Mol. Plant Pathol. 2022, 121, 101859. [Google Scholar] [CrossRef]
- Zhu, J.; Cao, A.; Wu, J.; Fang, W.; Huang, B.; Yan, D.; Wang, Q.; Li, Y. Effects of chloropicrin fumigation combined with biochar on soil bacterial and fungal communities and Fusarium oxysporum. Ecotoxicol. Environ. Saf. 2021, 220, 112414. [Google Scholar] [CrossRef] [PubMed]
- Ślusarski, C.; Spotti, C.A. Efficacy of chloropicrin application by drip irrigation in controlling the soil-borne diseases of greenhouse pepper on commercial farms in Poland. Crop Prot. 2016, 89, 216–222. [Google Scholar] [CrossRef]
- Goswami, D.G.; Kant, R.; Ammar, D.A.; Agarwal, C.; Gomez, J.; Agarwal, R.; Saba, L.M.; Fritz, K.S.; Tewari-Singh, N. Toxic consequences and oxidative protein carbonylation from chloropicrin exposure in human corneal epithelial cells. Toxicol. Lett. 2020, 322, 1–11. [Google Scholar] [CrossRef]
- Chalmers, B.T.; Merriman, A.F.; Ruff, A.L. Considerations for the optimization of in vitro models of chloropicrin toxicity. Arch. Toxicol. 2023, 97, 255–261. [Google Scholar] [CrossRef]
- Pesonen, M.; Vähäkangas, K. Chloropicrin-induced toxicity in the respiratory system. Toxicol. Lett. 2020, 323, 10–18. [Google Scholar] [CrossRef]
- Nadagouda, M.N.; Vijayasarathy, P.; Sin, A.; Nam, H.; Khan, S.; Parambath, J.B.M.; Mohamed, A.A.; Han, C. Antimicrobial activity of quaternary ammonium salts: Structure-activity relationship. Med. Chem. Res. 2022, 31, 1663–1678. [Google Scholar] [CrossRef]
- Brycki, B.E.; Kowalczyk, I.H.; Szulc, A.M.; Brycka, J.A. Quaternary Alkylammonium Salts as Cleaning and Disinfectant Agents. Quartäre Alkylammoniumsalze Reinig.-Desinfekt. 2018, 55, 432–438. [Google Scholar] [CrossRef]
- Gerba Charles, P. Quaternary Ammonium Biocides: Efficacy in Application. Appl. Environ. Microbiol. 2015, 81, 464–469. [Google Scholar] [CrossRef]
- Zhang, S.; Ding, S.; Yu, J.; Chen, X.; Lei, Q.; Fang, W. Antibacterial Activity, In Vitro Cytotoxicity, and Cell Cycle Arrest of Gemini Quaternary Ammonium Surfactants. Langmuir 2015, 31, 12161–12169. [Google Scholar] [CrossRef]
- Tischer, M.; Pradel, G.; Ohlsen, K.; Holzgrabe, U. Quaternary Ammonium Salts and Their Antimicrobial Potential: Targets or Nonspecific Interactions? ChemMedChem 2012, 7, 22–31. [Google Scholar] [CrossRef]
- Pérez-Rodríguez, M.; López Cabo, M.; Balsa-Canto, E.; García, M.R. Mechanisms of Listeria monocytogenes Disinfection with Benzalkonium Chloride: From Molecular Dynamics to Kinetics of Time-Kill Curves. Int. J. Mol. Sci. 2023, 24, 12132. [Google Scholar] [CrossRef]
- Merchel Piovesan Pereira, B.; Tagkopoulos, I. Benzalkonium Chlorides: Uses, Regulatory Status, and Microbial Resistance. Appl. Environ. Microbiol. 2019, 85, e00377-19. [Google Scholar] [CrossRef]
- Maillard, J.-Y. Impact of benzalkonium chloride, benzethonium chloride and chloroxylenol on bacterial antimicrobial resistance. J. Appl. Microbiol. 2022, 133, 3322–3346. [Google Scholar] [CrossRef]
- Gravel, J.; Paradis-Bleau, C.; Schmitzer, A.R. Adaptation of a bacterial membrane permeabilization assay for quantitative evaluation of benzalkonium chloride as a membrane-disrupting agent. MedChemComm 2017, 8, 1408–1413. [Google Scholar] [CrossRef]
- Bondurant, S.; McKinney, T.; Bondurant, L.; Fitzpatrick, L. Evaluation of a benzalkonium chloride hand sanitizer in reducing transient Staphylococcus aureus bacterial skin contamination in health care workers. Am. J. Infect. Control 2020, 48, 522–526. [Google Scholar] [CrossRef]
- Mizuno, H.; Mizutani, S.; Ekuni, D.; Tabata-Taniguchi, A.; Maruyama, T.; Yokoi, A.; Omori, C.; Shimizu, K.; Morimatsu, H.; Shirakawa, Y.; et al. New oral hygiene care regimen reduces postoperative oral bacteria count and number of days with elevated fever in ICU patients with esophageal cancer. J. Oral Sci. 2018, 60, 536–543. [Google Scholar] [CrossRef]
- Basaran, P. Inhibition effect of belzalkonium chloride treatment on growth of common food contaminating fungal species. J. Food Sci. Technol. 2011, 48, 515–519. [Google Scholar] [CrossRef][Green Version]
- Ray, M.; Dash, S.; Achary, K.G.; Nayak, S.; Singh, S. Development and evaluation of polyclonal antibodies for detection of Pythium aphanidermatum and Fusarium oxysporum in ginger. Food Agric. Immunol. 2018, 29, 204–215. [Google Scholar] [CrossRef]
- Ray, M.; Achary, K.G.; Nayak, S.; Singh, S. Development of a colloidal gold strip-based immunochromatographic assay for rapid detection of Fusarium oxysporum in ginger. J. Sci. Food Agric. 2019, 99, 6155–6166. [Google Scholar] [CrossRef]
- Athawale, V.; Paralikar, P.; Ingle, A.P.; Rai, M. Biogenically engineered nanoparticles inhibit Fusarium oxysporum causing soft-rot of ginger. IET Nanobiotechnol. 2018, 12, 1084–1089. [Google Scholar] [CrossRef]
- Panngom, K.; Lee, S.H.; Park, D.H.; Sim, G.B.; Kim, Y.H.; Uhm, H.S.; Park, G.; Choi, E.H. Non-Thermal Plasma Treatment Diminishes Fungal Viability and Up-Regulates Resistance Genes in a Plant Host. PLoS ONE 2014, 9, e99300. [Google Scholar] [CrossRef]
- Wen, G.; Xu, X.; Huang, T.; Zhu, H.; Ma, J. Inactivation of three genera of dominant fungal spores in groundwater using chlorine dioxide: Effectiveness, influencing factors, and mechanisms. Water Res. 2017, 125, 132–140. [Google Scholar] [CrossRef]
- Manzo-Valencia, M.K.; Valdés-Santiago, L.; Sánchez-Segura, L.; Guzmán-de-Peña, D.L. Naphthalene Acetic Acid Potassium Salt (NAA-K+) Affects Conidial Germination, Sporulation, Mycelial Growth, Cell Surface Morphology, and Viability of Fusarium oxysporum f. sp. radici-lycopersici and F. oxysporum f. sp. cubense In Vitro. J. Agric. Food Chem. 2016, 64, 8315–8323. [Google Scholar] [CrossRef]
- Yan, B.; Zhao, J.; Fan, D.; Tian, F.; Zhang, H.; Chen, W. Antifungal Activity of Lactobacillus plantarum against Penicillium roqueforti In Vitro and the Preservation Effect on Chinese Steamed Bread. J. Food Process. Preserv. 2017, 41, e12969. [Google Scholar] [CrossRef]
- Peng, Y.; Chang, J.; Xiao, Z.; Huang, J.; Xu, T.; Chen, S.; Fan, G.; Liao, S.; Wang, Z.; Luo, H. Synthesis and Antifungal Activity of Novel Tetrahydrogeranyl Quaternary Ammonium Salts. Nat. Prod. Commun. 2022, 17, 1934578X221078452. [Google Scholar] [CrossRef]
- Wilson, J.A.; Margolin, A.B. The efficacy of three common hospital liquid germicides to inactivate Cryptosporidium parvum oocysts. J. Hosp. Infect. 1999, 42, 231–237. [Google Scholar] [CrossRef]
- Rutala, W.; Gergen, M.; Gerding, D.; Weber, D.J. Effectiveness of Twenty Germicides Against Five Strains of C. difficile spores, with and without Calf Serum, at Several Exposure Times. Infect. Control Hosp. Epidemiol. 2020, 41 (Suppl. S1), s204–s206. [Google Scholar] [CrossRef]
- Visconti, V.; Rigalma, K.; Coton, E.; Dantigny, P. Impact of temperature application and concentration of commercial sanitizers on inactivation of food-plant fungal spores. Int. J. Food Microbiol. 2022, 366, 109560. [Google Scholar] [CrossRef]
- Hill, T.B.; Daniels, G.C.; Feng, J.; Harding, M.W. Hard to Kill: Inactivation of Plasmodiophora brassicae Resting Spores Using Chemical Disinfectants. Plant Dis. 2021, 106, 190–196. [Google Scholar] [CrossRef]
- Vági, P.; Caffi, T.; Váczy, K.Z.; Németh, M.Z.; Kiss, L. Refining a method for ascospore viability testing in overwintering chasmothecia of Erysiphe necator. Eur. J. Plant Pathol. 2016, 144, 799–802. [Google Scholar] [CrossRef]
- Kumari, M.; Shukla, S.; Pandey, S.; Giri, V.P.; Bhatia, A.; Tripathi, T.; Kakkar, P.; Nautiyal, C.S.; Mishra, A. Enhanced Cellular Internalization: A Bactericidal Mechanism More Relative to Biogenic Nanoparticles than Chemical Counterparts. ACS Appl. Mater. Interfaces 2017, 9, 4519–4533. [Google Scholar] [CrossRef]
- Xing, K.; Xing, Y.; Liu, Y.; Zhang, Y.; Shen, X.; Li, X.; Miao, X.; Feng, Z.; Peng, X.; Qin, S. Fungicidal effect of chitosan via inducing membrane disturbance against Ceratocystis fimbriata. Carbohydr. Polym. 2018, 192, 95–103. [Google Scholar] [CrossRef]
- Zuo, J.; Xu, X.; Wan, Q.; Cao, R.; Liang, Z.; Xu, H.; Li, K.; Huang, T.; Wen, G.; Ma, J. Inactivation of fungal spores in water with peracetic acid: Efficiency and mechanism. Chem. Eng. J. 2022, 427, 131753. [Google Scholar] [CrossRef]
- Oliveira, B.R.; Barreto Crespo, M.T.; Pereira, V.J. Small but powerful: Light-emitting diodes for inactivation of Aspergillus species in real water matrices. Water Res. 2020, 168, 115108. [Google Scholar] [CrossRef]
- Wen, G.; Kötzsch, S.; Vital, M.; Egli, T.; Ma, J. BioMig—A Method to Evaluate the Potential Release of Compounds from and the Formation of Biofilms on Polymeric Materials in Contact with Drinking Water. Environ. Sci. Technol. 2015, 49, 11659–11669. [Google Scholar] [CrossRef]
- Gallagher, A.G.; McLean, K.; Stewart, R.M.K.; Wellings, D.A.; Allison, H.E.; Williams, R.L. Development of a Poly-ε-Lysine Contact Lens as a Drug Delivery Device for the Treatment of Fungal Keratitis. Investig. Ophthalmol. Vis. Sci. 2017, 58, 4499–4505. [Google Scholar] [CrossRef]
- Zhang, C.; Brown, P.J.B.; Miles, R.J.; White, T.A.; Grant, D.G.; Stalla, D.; Hu, Z. Inhibition of regrowth of planktonic and biofilm bacteria after peracetic acid disinfection. Water Res. 2019, 149, 640–649. [Google Scholar] [CrossRef]
- Marks, C.A. Fumigation of rabbit warrens with chloropicrin produces poor welfare outcomes a review. Wildl. Res. 2009, 36, 342–352. [Google Scholar] [CrossRef]
- Wen, G.; Cao, R.; Wan, Q.; Tan, L.; Xu, X.; Wang, J.; Huang, T. Development of fungal spore staining methods for flow cytometric quantification and their application in chlorine-based disinfection. Chemosphere 2020, 243, 125453. [Google Scholar] [CrossRef]
- Xu, X.; Zuo, J.; Wan, Q.; Cao, R.; Xu, H.; Li, K.; Huang, T.; Wen, G.; Ma, J. Effective inactivation of fungal spores by the combined UV/PAA: Synergistic effect and mechanisms. J. Hazard. Mater. 2022, 430, 128515. [Google Scholar] [CrossRef]
- Liang, Z.; Xu, X.; Cao, R.; Wan, Q.; Xu, H.; Wang, J.; Lin, Y.; Huang, T.; Wen, G. Synergistic effect of ozone and chlorine on inactivating fungal spores: Influencing factors and mechanisms. J. Hazard. Mater. 2021, 420, 126610. [Google Scholar] [CrossRef]
- Khan, A.H.; Macfie, S.M.; Ray, M.B. Sorption and leaching of benzalkonium chlorides in agricultural soils. J. Environ. Manag. 2017, 196, 26–35. [Google Scholar] [CrossRef]
- Brycki, B.; Waligórska, M.; Szulc, A. The biodegradation of monomeric and dimeric alkylammonium surfactants. J. Hazard. Mater. 2014, 280, 797–815. [Google Scholar] [CrossRef]
- Cui, Y.; Gao, J.; Zhao, M.; Guo, Y.; Zhao, Y.; Wang, Z. Deciphering the interaction impacts between antiseptic benzethonium chloride and biofilm nitrification system: Performance, resistance mechanisms and biodegradation. Water Res. 2023, 240, 120062. [Google Scholar] [CrossRef]
- Hong, J.-M.; Xia, Y.-F.; Zhang, Q.; Chen, B.-Y. Oxidation of benzalkonium chloride in aqueous solution by S2O82−/Fe2+ process: Degradation pathway, and toxicity evaluation. J. Taiwan Inst. Chem. Eng. 2017, 78, 230–239. [Google Scholar] [CrossRef]

Disclaimer/Publisher’s Note: The statements, opinions and data contained in all publications are solely those of the individual author(s) and contributor(s) and not of MDPI and/or the editor(s). MDPI and/or the editor(s) disclaim responsibility for any injury to people or property resulting from any ideas, methods, instructions or products referred to in the content. |
© 2023 by the authors. Licensee MDPI, Basel, Switzerland. This article is an open access article distributed under the terms and conditions of the Creative Commons Attribution (CC BY) license (https://creativecommons.org/licenses/by/4.0/).
Share and Cite
Zhao, D.; Zhang, Y.; Jin, Z.; Bai, R.; Wang, J.; Wu, L.; He, Y. Benzalkonium Chloride and Benzethonium Chloride Effectively Reduce Spore Germination of Ginger Soft Rot Pathogens: Fusarium solani and Fusarium oxysporum. J. Fungi 2024, 10, 8. https://doi.org/10.3390/jof10010008
Zhao D, Zhang Y, Jin Z, Bai R, Wang J, Wu L, He Y. Benzalkonium Chloride and Benzethonium Chloride Effectively Reduce Spore Germination of Ginger Soft Rot Pathogens: Fusarium solani and Fusarium oxysporum. Journal of Fungi. 2024; 10(1):8. https://doi.org/10.3390/jof10010008
Chicago/Turabian StyleZhao, Dongxu, Yang Zhang, Zhaoyang Jin, Ruxiao Bai, Jun Wang, Li Wu, and Yujian He. 2024. "Benzalkonium Chloride and Benzethonium Chloride Effectively Reduce Spore Germination of Ginger Soft Rot Pathogens: Fusarium solani and Fusarium oxysporum" Journal of Fungi 10, no. 1: 8. https://doi.org/10.3390/jof10010008
APA StyleZhao, D., Zhang, Y., Jin, Z., Bai, R., Wang, J., Wu, L., & He, Y. (2024). Benzalkonium Chloride and Benzethonium Chloride Effectively Reduce Spore Germination of Ginger Soft Rot Pathogens: Fusarium solani and Fusarium oxysporum. Journal of Fungi, 10(1), 8. https://doi.org/10.3390/jof10010008

